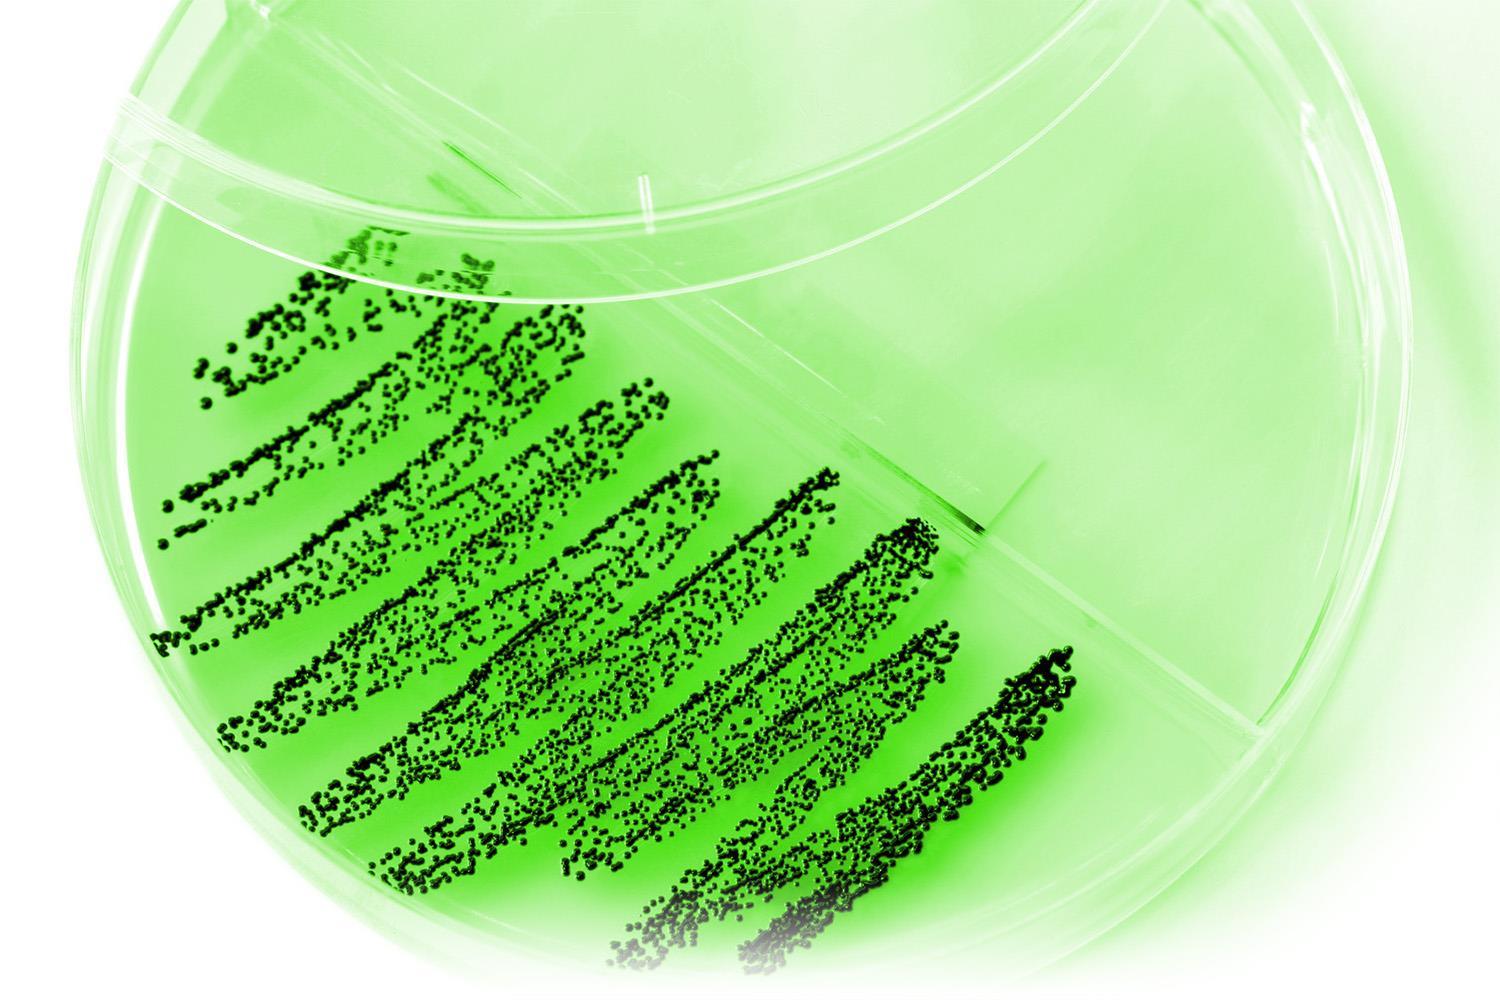

![WiduMed Müller-Hinton Agar [20 Stück] WiduMed Müller-Hinton Agar [20 Stück]](https://www.vetshop.de/media/c1/eb/10/1685080561/118674_fotolia_1.jpeg?ts=1685080561)
![WiduMed Müller-Hinton Agar [20 Stück] WiduMed Müller-Hinton Agar [20 Stück]](https://www.vetshop.de/media/c1/eb/10/1685080561/118674_fotolia_1.jpeg?ts=1685080561)

WiduMed Müller-Hinton Agar [20 Stück]
Preise erst nach Anmeldung sichtbar.
Produktnummer:
118674
Hersteller-Nr.:
WI-AG-16
Zubehör
- Fertignährboden nach Müller-Hinton Agar
- Geeignet zur Resistenzbestimmung
- Inhalt 20 Platten
- Lagerungstemperatur 8 bis 15 °C
Angaben zum Hersteller (Informationspflichten zur GPSR Produktsicherheitsverordnung)

Widufit GmbH
Dieselstrasse 9
32289 Rödinghausen, DE
05223-6533623
www.widufit.de
info@widufit.de
Dieselstrasse 9
32289 Rödinghausen, DE
05223-6533623
www.widufit.de
info@widufit.de